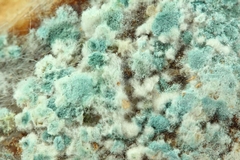
Green Mold: Causes, Identification, and Removal

Green Mold: Causes, Identification, and Removal
Mold is a frequent but often unwelcome guest in homes and businesses alike, with green mold standing out as a particularly stubborn and unsightly variety. What exactly causes this colorful invader to appear, and how can you identify and remove it effectively? Understanding the answers to these questions is crucial, especially for homeowners and property managers in Boise. As a leader in damage restoration services in Boise, ID, Idaho Fire & Flood offers insights into dealing with this common issue effectively. This blog post will explore the causes of green mold, how to identify it, and the best removal strategies to keep your property safe and mold-free.
Understanding Green Mold
Green mold is a general term used to describe various species of mold that appear in shades of green. While it sounds harmless, green mold can pose serious health risks and damage to property. Mold thrives in damp and humid conditions - common culprits being leaky roofs, poor ventilation, or undetected water damage. Understanding the environmental conditions that promote mold growth is vital to both prevention and removal.
Molds such as Aspergillus, Penicillium, and Cladosporium are frequently the ones that manifest as green mold. These species can often settle in kitchens, bathrooms, and basements where the conditions are just right: high humidity and low ventilation. Particularly in places like Boise, where variances in season can contribute to fluctuating moisture levels, paying regular attention to your environment can help manage potential outbreaks.
Causes of Green Mold
Environmental Conditions
Green mold, like its many counterparts, flourishes in environments rich in moisture. Common causes include water intrusion from leaks, poor drainage, or condensation build-up. The breakdown or failure of heating, ventilation, and air conditioning systems can also create an ideal breeding ground for green mold. Homeowners in Boise, ID, need to be especially vigilant during the wetter months or after significant weather events when humidity levels spike.
Poor Maintenance
Regular home maintenance plays a crucial role in preventing mold outbreaks. Gutters that overflow, roofs with leaks, and interiors with insufficient ventilation are frequent contributors to the growth of green mold. Routine inspections and timely repairs are fundamental practices for property upkeep.
Water Damage
Whether from a slowly leaking pipe or as a result of a sudden overflow, water damage can be a catalyst for mold. Addressing water damage promptly is crucial: never underestimate the need for professional water damage restoration. For residents of Boise who encounter mold as a result of water damage, quick action can prevent a minor issue from turning into a major one.
Identification of Green Mold
Identifying green mold can sometimes be straightforward, but distinguishing its risks may not be as obvious. Mold is often identified by its visual characteristics - a patchy or fuzzy surface with variations in shades of green ranging from dark forest hues to pale, almost white tones. However, do not rely solely on appearance; mold can also present with a musty or earthy smell.
Sometimes, the extent of green mold presence isn't obvious and can affect hidden areas like behind wallpaper or under carpets. Professional assessment from qualified mold remediation experts is the best practice to determine the full scope of the problem. Images of mold often portray a clear view of what to look for; for educational purposes, homeowners can benefit from field guides or online resources showcasing local mold types.
Removing Green Mold
Basic Steps for Mold Removal
- Identify and Address Moisture Sources: Before removing the mold, locate the moisture source and address it. This might involve fixing leaks or improving ventilation.
- Ventilate the Area: Ensure the affected area is well-ventilated. Open windows and use fans to increase airflow and reduce humidity.
- Safety Gear: Mold can pose health risks, so use proper safety gear such as gloves, goggles, and masks when dealing with mold.
- Scrub Mold with Cleaning Solution: A mixture of water and detergent or a specialized mold remover can be effective. Scrub the mold thoroughly and rinse the area with clean water.
- Dry Thoroughly: After cleaning, the area must be dried completely to prevent mold regrowth.
Professional Mold Remediation
In some cases, especially where mold has penetrated deeply or grown extensively, professional mold remediation and cleanup are necessary. Attempting large-scale mold removal without proper expertise can lead to further damage or health issues. In these situations, experts like Idaho Fire & Flood offer comprehensive services that include water damage restoration in Boise and its nearby areas, ensuring all mold traces are thoroughly removed along with preventive measures.
Preventative Strategies
To keep green mold at bay, consider these proactive strategies:
- Regular Inspections: Conduct periodic inspections for moisture hotspots. Be proactive, especially in areas prone to leaks or high humidity.
- Improve Ventilation: Place dehumidifiers in particularly damp areas like basements to control humidity levels.
- Maintain Home Systems: Regular maintenance of HVAC systems is essential to avoiding mold-friendly environments.
- Educate Yourself and Your Family: Understanding the signs and risks associated with mold can increase your responsiveness to potential threats.
Why Choose Professional Help?
Dealing with green mold goes beyond simple soap and water solutions. The complexity of mold contamination sometimes requires a deeper, professional approach to ensure safety and thoroughness. Idaho Fire & Flood’s services go beyond simple removal to include comprehensive site evaluations and remediation, determining the best strategy to protect your property. With expertise in mold remediation in areas such as Eagle and its surrounding areas, Idaho Fire & Flood stands ready to assist you in maintaining a safe and healthy environment.
Regular inspection and timely intervention are your best defenses against mold-related threats. Should you find yourself confronted with the challenges of mold, remember that Idaho Fire & Flood is eager to assist you in resolving these issues comprehensively and efficiently. For all your mold-related concerns, reach out today to safeguard your property against the persistent nuances of green mold.
Recent Posts
-
Tips to Deal With Insurance Adjuster After a House Fire
June 03, 2026
-
How to Remove Mold From Bathroom Ceiling Step by Step
June 01, 2026
-
Cat 2 Water Damage: Why This Contamination Level Is Serious
May 17, 2026